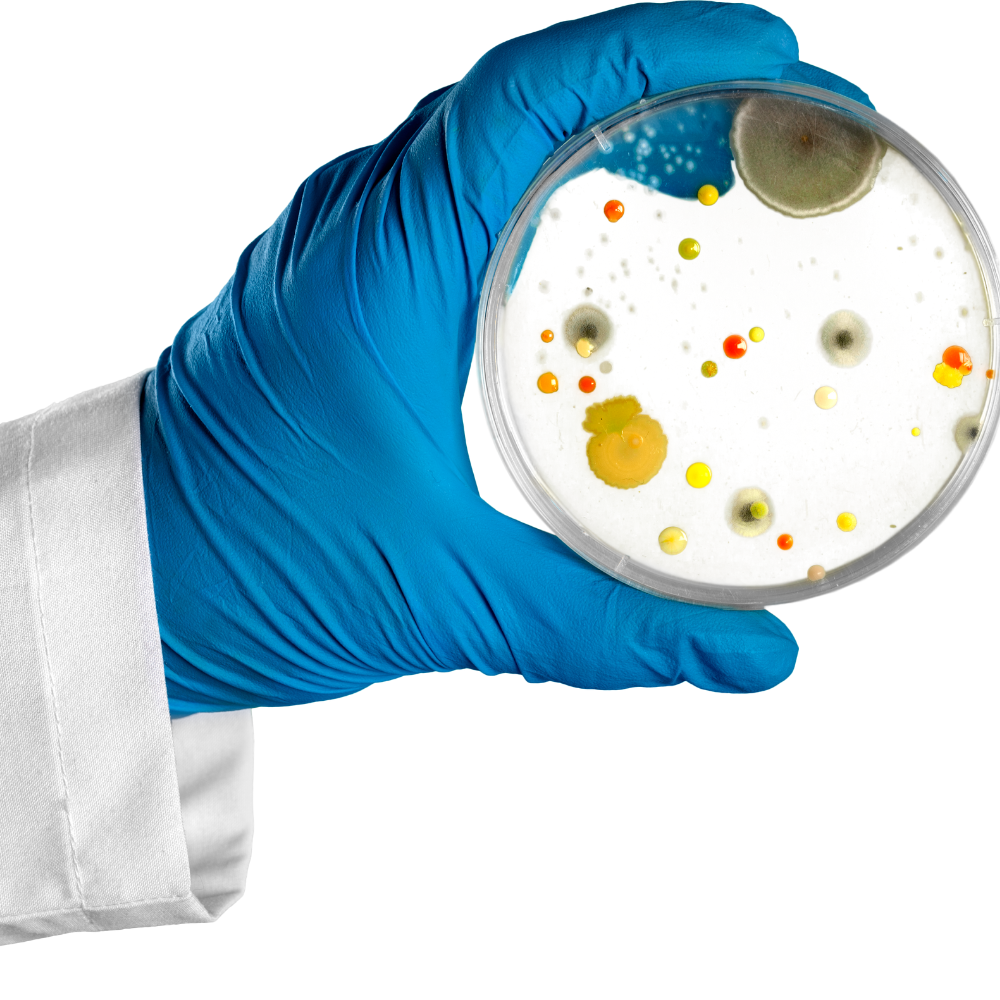

What Bacteria Causes Tooth Decay?
Your teeth have to be tough in order to stand up to the constant use over the course of your lifetime. Fortunately, they're protected by an outer surface called enamel. But even though enamel is one of the hardest materials in your body, it's still vulnerable to damage. Tooth decay happens when your enamel is damaged by acids in your mouth from foods or bacteria.
The early symptoms of decay include toothaches and sensitivity to heat or cold. Left unchecked, enamel damage can lead to cavities, pain, infection and even lost teeth.
Tooth decay is a cumulative problem that won't heal or go away on its own. Once your enamel is damaged, the tooth will continue to decay until it's treated by a dentist. One of the best things you can do for your dental health is to get rid of the bacteria that causes tooth decay before it starts.
The Most Common Tooth Decay Bacteria
Your mouth is literally teeming with bacteria. Most of them are harmless or even beneficial to your mouth ecosystem, but some can cause trouble. Streptococcus mutans is the bacteria primarily responsible for tooth decay.
These bacteria band together to share a food source and work as a team. They stick your teeth and form plaque. Any sugars or starches you eat become food for the Streptococcus mutans, and they produce acids that begin to damage your enamel and demineralize your teeth.
How to Prevent Tooth Decay
Since tooth decay can't be reversed, you'll want to work hard to prevent it from starting. Here are some tips for managing your mouth bacteria and keeping decay at bay.
1. Brush Your Teeth With Fluoridated Toothpaste
Dentists recommend you brush your teeth for two to three minutes at least twice per day. You should use toothpaste with fluoride, which replaces some of the minerals in your teeth and helps the enamel repair itself.
2. Floss Every Time You Brush
Flossing is also vital. Tooth decay bacteria like to hide in tough-to-reach places, like between your teeth, along your gum line and in any crevices. Your floss should help you clean these areas to eliminate the bacteria.
3. Keep Orthodontic Devices Clean
Clean devices like dentures, aligners, retainers and mouth guards thoroughly to ensure they aren't harboring harmful bacteria that could lead to tooth decay.
EverSmile carries an assortment of cleaning products designed specifically for cleaning orthodontic devices. These products kill up to 99.999% of the bacteria that causes decay.
4. Watch What You Eat
Cut back on foods with sugars and starches that feed the bacteria. Instead, eat foods rich in fiber that stimulate saliva production, like celery, carrots and apples. Saliva helps to protect your enamel from the acids produced by bacteria.
Combat Tooth Decay With EverSmile
EverSmile products are developed by orthodontists to help everyone achieve a clean, healthy smile free of tooth decay. Our products include cleansers for orthodontic devices and our WhitenFresh breath spray that kills the bacteria in your mouth and leaves you with fresh breath.
Shop our online catalog to find the perfect product to help keep your teeth in great shape.
Related Articles
-

Foods to Eat for Improved Tooth Health
You've heard the saying, "You are what you eat," and this is true when it comes to your dental health. Your dental health and the diet you consume go hand in hand. You can include tooth-friendly foods in your regular diet to support your daily oral...
Read More -

Why Does Having Straight Teeth Matter? 12 Health Benefits of Straight Teeth
If you're one of 81% of adults that think their teeth are unattractive when they see them in photographs, it might feel good to know you're not alone. But it still doesn't change how you feel. Many adults are self-conscious about their smiles because they don't...
Read More -

Top Reasons You Shouldn't Sleep With Dentures
Perhaps it's been a long day, and you're tired. Or, maybe you don't like to be without teeth. What's the harm in leaving your dentures in overnight? There's a reason your dentist recommends removing your dentures for at least five to six hours per day and...
Read More -

What Bacteria Causes Tooth Decay?
Your teeth have to be tough in order to stand up to the constant use over the course of your lifetime. Fortunately, they're protected by an outer surface called enamel. But even though enamel is one of the hardest materials in your body, it's still...
Read More -

How to Fix Bad Breath
Bad breath is an all-too-common issue that affects almost everyone from time to time. This condition can be temporary or chronic, and it is also referred to as oral malodor or halitosis. Many people experience bad breath in the morning when they first wake up,...
Read More -

What Your Teeth Say About Your Ancestry
The shape, configuration and landscape of each person's teeth are unique to them. Your teeth are shaped by your genetics and then altered and worn by the food you eat and how you live your life. Your dentist can tell a lot about your personal...
Read More -

6 Interesting Facts to Know About Your Dental Health
Our teeth grow in within the first few months of our lives. From that point on, we use and care for them every day. Even with all that experience, there are still things many of us don't know about our teeth. Dental Health Facts You...
Read More

Post a Comment!